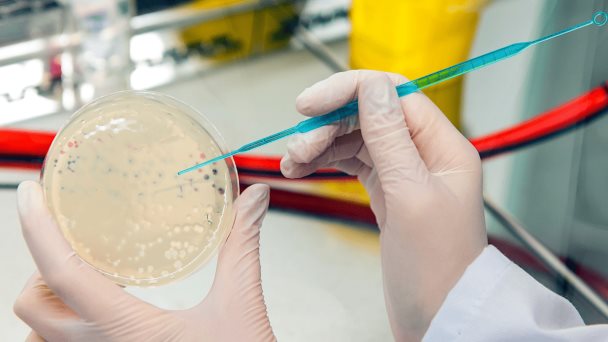
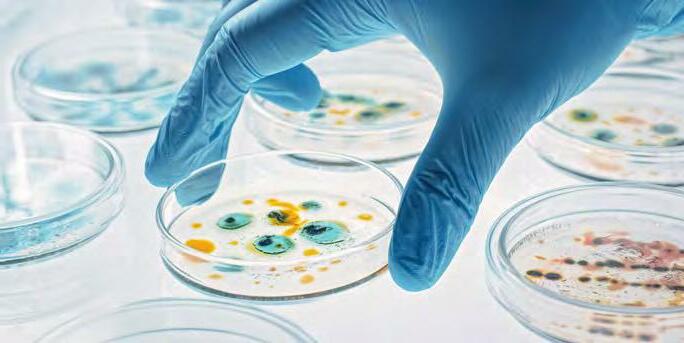

Subprograma 4 – Control biológico utilizando bacteriófagos y/o sus derivados para patógenos bacterianos principales (transmitidos por alimentos y/o resistentes a antibióticos)
El subprograma investiga soluciones biotecnológicas frente a la resistencia antimicrobiana desde el enfoque One Health, desarrollando bioproductos basados en bacteriófagos y enzimas líticas mediante investigación, formación académica y aplicaciones orientadas a la seguridad alimentaria y la salud pública.
Coordinación
María Teresa Álvarez
- Instituto de Investigaciones Fármaco Bioquimicas
- mariateresa.alvarezaliaga@gmail.com
- Perfil Scopus
Dan I. Andersson
- Department of Medical Biochemistry and Microbiology (IMBIM)
- Uppsala University / Suecia
Daniel Martin Salas
- Instituto de Investigaciones Fármaco Bioquimicas
- danielsalasbo@gmail.com
Karin Hjort
- Department of Medical Biochemistry and Microbiology (IMBIM)
- Uppsala University / Suecia
Doctorando
Marcelo Fernando Gutierrez Valverde
Objetivo general
Desarrollar alternativas biotecnológicas innovadoras basadas en el uso de bacteriófagos y sus derivados (como endolisinas y depolimerasas) para el control de bacterias patógenas transmitidas por alimentos y resistentes a antibióticos, contribuyendo a la reducción del uso de antimicrobianos en la producción agroalimentaria y al fortalecimiento de la salud pública y ambiental en Bolivia.
Objetivos específicos
Primero
Fortalecer la formación de recursos humanos en investigación científica y tecnológica en el área de resistencia antimicrobiana, ingeniería genética, biología sintética e ingeniería de proteínas, mediante la formación de doctorandos, maestrantes y tesistas de licenciatura.
Segundo
Aislar y caracterizar bacteriófagos y enzimas derivadas con potencial aplicación en el control biológico de Salmonella spp., Escherichia coli y Campylobacter jejuni.
Tercero
Implementar estudios de expresión, purificación y evaluación de proteínas líticas (endolisinas y depolimerasas) para determinar su eficacia antimicrobiana.
Cuarto
Consolidar la cooperación internacional entre UMSA y Uppsala University mediante investigación conjunta, transferencia de conocimiento y movilidad académica.
Quinto
Promover la sensibilización pública y académica sobre la resistencia antimicrobiana en el contexto “One Health” mediante cursos, talleres y simposios.
Poryectos
Doctorales
Maestría
Grado
Apalancados
Artículos científicos en revistas internacionales indexadas
Artículos científicos publicados en revistas nacionales
Participación en eventos científicos internacionales
Participación en eventos científicos nacionales
Detalles
Unidades Ejecutoras
Facultad de Ciencias Farmacéuticas y Bioquímicas – Instituto de Investigaciones Fármaco Bioquímicas (IIFB), Universidad Mayor de San Andrés.
Socios locales
- Facultad de Ciencias Farmacéuticas y Bioquímicas – UMSA
- AGEMED – Agencia Estatal de Medicamentos y Tecnología en Salud
- Sociedad Científica de Estudiantes de Ingeniería Química, Alimentos y Ambiental (SOCEIQAAP)
- Laboratorios locales y unidades de análisis microbiológico
- Gobiernos municipales del Departamento de La Paz (proyectos de monitoreo de agua y saneamiento)
Socios internacionales
- Uppsala University (Suecia) – Department of Medical Biochemistry and Microbiology
- Swedish Research Council (Vetenskapsrådet)
- Institut Pasteur de Montevideo (Uruguay)
- GIZ – Deutsche Gesellschaft für Internationale Zusammenarbeit (Alemania)
- UNESCO–TWAS (Italia)
Cursos organizados
10 cursos o eventos organizados.
Premios
8 premios obtenidos.
Resultados y producción
Consolidado 2021–2025: equipo, proyectos, publicaciones, eventos y reconocimientos.
Integrantes del subprograma
Gestión 2025| Nº | Nombre completo | Rol / Cargo |
|---|---|---|
| 1 | Maria Teresa Álvarez Aliaga | Coordinadora |
| 2 | Dan Andersson | Coordinador en Suecia |
| 3 | Daniel Martin Salas Veizaga | Co-coordinador |
| 4 | Karin Hjort | Co-coordinadora en Suecia |
| 5 | Marcelo Fernando Gutierrez Valverde | Doctorando |
| 6 | Yuran Elias Calancha Padrón | Estudiante de Maestría |
| 7 | Dayana Pérez Condori | Estudiante de Maestría |
| 8 | Ariel Jesus De la Fuente Arias | Investigador Asociado |
| 9 | Tatiana Marisol Callejas Icuña | Investigador |
| 10 | Jonatan Joel Aliaga Rodríguez | Investigador |
| 11 | Araceli Avendaño Rivera | Estudiante de pregrado |
| 12 | Abigail Chuilla Condori | Investigadora |
| 13 | Abelardo Hermogenes Mamani Tacachira | Estudiante de pregrado |
| 14 | Mariela Sanchez Bosque | Estudiante de pregrado |
| 15 | Estefani Huanca Guzmán | Estudiante de pregrado |
| 16 | Emmanuel Gonzalo Contreras Gonzales | Estudiante de pregrado |
| 17 | Maya Orellana Quispe | Estudiante de pregrado |
| 18 | Aryana Chávez Alanoca | Estudiante de pregrado |
| 19 | Cristell Jaimes | Estudiante de pregrado |
| 20 | Roberto Majluf Rossel | Estudiante de pregrado |
| 21 | April Isabel Villegas Cussi | Investigador |
| 22 | Adriana Lizeth Ramos Tito | Beca auxiliatura |
| 23 | Lizeth Pamela Laura Mejía | Investigadora |
| 24 | Leonardo Roberto Rocabado Villegas | Investigador |
| 25 | Valeria Alejandra Navia Fernandez | Investigador |
| 26 | Nayla Rubi Apaza Álvarez | Estudiante de Maestría |
| 27 | Cinthia Lucia Quispe Silva | Investigadora |
Proyectos doctorales
Resultados 2021–2025| Título | Tipo | Autor | Estado | Financiador |
|---|---|---|---|---|
| Enzibióticos bacteriófagos (endolisinas) para el tratamiento y control de infecciones bacterianas transmitidas por alimentos y/o resistentes a los antimicrobianos | Doctoral | Gutierrez Valverde Marcelo Fernando | En curso | ASDI / UMSA / UPPSALA |
Proyectos de maestría
Resultados 2021–2025| Título | Tipo | Autor | Estado | Financiador |
|---|---|---|---|---|
| Establecimiento de una estrategia de control biológico de cepas ambientales de Salmonella spp. resistentes a antibióticos mediante la aplicación de bacteriófagos líticos | Maestría | Luque Cruz Pamela | Concluido | Asdi–UMSA |
| Proyecto de maestría (título no reportado) | Maestría | Calancha Padron Yuran Elias | En curso | Asdi–UMSA |
| Proyecto de maestría (título no reportado) | Maestría | Laura Mejia Lizeth Pamela | En curso | Asdi–UMSA |
| Proyecto de maestría (título no reportado) | Maestría | Apaza Alvarez Nayla Rubi | En curso | Asdi–UMSA |
Proyectos de Grado Licenciatura
Resultados 2021–2025| Título | Tipo | Autor | Estado | Financiador |
|---|---|---|---|---|
| Establecimiento de un banco de bacteriófagos líticos como potenciales controladores biológicos eficaces contra la proliferación de cepas de Escherichia coli resistentes a antibióticos | Grado | Dayana Perez Condori | Concluido | Asdi-UMSA |
| Estudio de la resistencia antimicrobiana en aguas superficiales del río La Paz durante el periodo de mayo 2021 – agosto 2022, en el contexto de la pandemia COVID-19 | Grado | Abigail Chuilla Condori | Concluido | Asdi-UMSA |
| Relación entre la exposición a especies de cloro libre con la resistencia a los antibióticos de bacterias heterotróficas aisladas a partir de puntos de distribución de agua potable de las ciudades de La Paz y El Alto – Bolivia | Grado | Jonatan Joel Aliaga Rodríguez | Concluido | Asdi-UMSA |
| Determinación de genes relacionados a la virulencia del fitopatógeno Fusarium spp. causante de la marchitez vascular en cultivos de Erythroxylum coca de las regiones subtropicales y tropicales de Bolivia | Grado | April Isabel Villegas Cussi | Concluido | Asdi-UMSA |
| Estudio del potencial de bacteriófagos líticos como herramientas de control biológico de Campylobacter spp. resistentes a antibióticos | Grado | Calancha Padron Yuran Elias | Concluido | Asdi-UMSA |
| Evaluación de la actividad biológica inhibitoria de filtrados producidos por cultivos inmovilizados en agar-agar de Bacillus sp. contra Phytophthora spp. como patógeno foliar del tomate | Grado | Ruth Paola Arteaga Arteaga | Concluido | Asdi-UMSA |
Proyectos apalancados
Resultados 2021–2025| Título | Tipo | Estado | Financiador |
|---|---|---|---|
| CotriSan – Estrategia de saneamiento en ciudades intermedias | Apalancado | Concluido | GIZ – 50,000 € approx. |
| Proyecto Microtoxbol – Microbiomas humanos para tolerar Arsenico como un potente tóxico | Apalancado | Concluido | SRC |
| Producción enzimática recombinante para biorrefinería en Bolivia | Apalancado | Concluido | UNESCO–TWAS |
| Diagnóstico de la calidad de agua para consumo humano en La Paz | Apalancado | En curso | IDH |
| Investigación de genes de resistencia antibiótica en miel y propóleo, Ecorefugio de abejas nativas La Paz, Coroico | Apalancado | En curso | IDH |
| Estrategias de biorremediación de la resistencia antimicrobiana en excretas hospitalarias | Apalancado | En curso | IDH |
| Red regional para la vigilancia y monitoreo de enfermedades emergentes (FSPI) | Apalancado | Concluido | FSPI – Institut Pasteur Montevideo |
Artículos internacionales indexados
6 publicaciones (2021–2026)| Artículo | Autores | Revista / Indexación | Fecha | Enlace |
|---|---|---|---|---|
| Producción de ácido propiónico a partir de glicerol en biorreactor de células inmovilizadas utilizando una cepa de Propionibacterium acidipropionici tolerante al ácido obtenida por evolución adaptativa | Víctor Hugo Cavero-Olguín, Farshad Rahimpour, Tarek Dishisha, María Teresa Álvarez Aliaga, Rajni Hatti-Kaul | Process Biochemistry Scopus |
11/11/2021 | Ver |
| Revisión sistemática y metaanálisis: la eficacia de los bacteriófagos previamente patentados contra bacterias patógenas en los alimentos | Danitza Xiomara Romero-Calle, Vinicius Pereira de Santana, Raquel Guimarães Benevides, María Teresa Álvarez Aliaga, Craig Billington y Aristóteles Góes-Neto | Systematic Reviews Scopus |
28/10/2023 | Ver |
| Una nueva enzima similar a la glucósido hidrolasa 43 de Clostridium boliviensis es una endoxilanasa y una candidata para la producción de xilooligosacáridos a partir de diferentes sustratos de xilano | Daniel Martin Salas-Veizaga, Leonardo Roberto Rocabado-Villegas, Javier A. Linares-Pastén, Elisabet Eik Gudmundsdottir, Gudmundur Oli Hreggvidsson, María Teresa Álvarez-Aliaga, Patrick Adlercreutz, Eva Nordberg Karlsson | Applied and Environmental Microbiology Scopus |
18/03/2024 | Ver |
| Cambios en el transcriptoma sanguíneo relacionados con la exposición prolongada al arsénico a través del agua potable: un estudio transversal realizado en los Andes bolivianos | Ying Yang, Anastasiia Snigireva, Jessika Barron, Noemi Tirado, Maria Teresa Alvarez Aliaga, Gina Torres, Paolo Manghi, Philippe Gérard, Michael Levi, Jacques Gardon, Harri Alenius, Karin Broberg | Environment International Scopus |
01/09/2025 | Ver |
| Nanopartículas de cobre biogénicas como nueva estrategia de control biológico para la plaga de Ascochyta en garbanzos | Paulina L. Páez, Carina Vasquez-Espejo, M. Florencia Sardo, M. Teresa Álvarez-Aliaga, Mariela I. Monteoliva, Lucio Valetti | Plant Nano Biology Scopus |
01/02/2026 | Ver |
| Aislamiento y caracterización de nuevos bacteriófagos líticos contra cepas de Campylobacter resistentes a las (fluoro)quinolonas | Yuran Elías Calancha-Padrón, Dayana Perez-Condori, Marcelo Fernando Gutierrez-Valverde, Daniel Martin Salas-Veizaga, Karin Hjort, María Teresa Alvarez-Aliaga | Frontiers in Microbiology Scopus |
01/01/2026 | Ver |
Artículos científicos publicados en revistas nacionales
2 publicaciones (2023–2025)| Artículo | Autores | Revista | Fecha | Enlace |
|---|---|---|---|---|
| Eficacia de los productos bio-basados en fagos en el control de patógenos transmitidos por alimentos | Pamela Luque Cruz, María Teresa Álvarez Aliaga | Revista Con-Ciencia | 20/06/2024 | Ver |
Participación en eventos científicos internacionales
Presentaciones y participación 2021–2025| Nombre del evento | Expositores / Ponentes | Formato | País | Ciudad | Año |
|---|---|---|---|---|---|
| Reunión Final – Proyecto Microtoxbol | Leonardo Rocabado; María Teresa Álvarez | Exposición | Suecia | — | 2023 |
| Informe Final – Red Regional de Vigilancia – Instituto Pasteur Montevideo | Daniel Salas Veizaga; María Teresa Álvarez | Exposición | Uruguay | Montevideo | 2023 |
| Workshop – Gran Reunión del Programa de Asesoramiento | Marcelo Gutiérrez Valverde | Exposición | Suecia | — | 2024 |
| V Semana de la Biotecnología – UNIFESP | Mariela Sánchez | Exposición | Brasil | Baixada Santista, Santos | 2024 |
Participación en eventos científicos nacionales
Presentaciones y participación 2021–2025| Nombre del evento | Expositores / Ponentes | Formato | País | Ciudad | Año |
|---|---|---|---|---|---|
| IV Jornadas Científicas Julianas – UMSA | Yuran Calancha, Dayana Pérez, Abigail Chuilla | Exposición | Bolivia | La Paz | 2022 |
| Jornadas de Jóvenes Investigadores – AUGM | Abigail Chuilla, Dayana Pérez, Jhon Nina, Nayla Rubí Apaza, Ruth Arteaga, Valeria Navia, Yuran Calancha, Yuran Elias Calancha | Exposición | Bolivia | Sucre | 2022 |
| Congreso Científico Nacional de Estudiantes de Bioquímica y Farmacia – USFX | Abigail Chuilla, Yuran Calancha | Exposición | Bolivia | Sucre | 2022 |
| Congreso Científico Facultativo “Rolando Sánchez” – UMSA | Pamela Luque, Yuran Calancha, Abigail Chuilla | Exposición | Bolivia | La Paz | 2022 |
| Congreso Científico Nacional de Estudiantes de Bioquímica y Farmacia – UMSS | Abigail Chuilla, Dayana Pérez | Exposición | Bolivia | Cochabamba | 2023 |
| VI Jornadas Científicas Julianas – UMSA | Yuran Calancha | Exposición | Bolivia | La Paz | 2024 |
| XXVIII Congreso Nacional de Sociedades Científicas de Estudiantes de Ciencias Farmacéuticas y Bioquímicas | Stephany Huanca | Exposición | Bolivia | Sucre | 2024 |
| XXVIII Congreso Boliviano Científico de Estudiantes de Ciencias Farmacéuticas y Bioquímicas (COBOLCEFYB) | Estefani Huanca, Mariela Sánchez | Exposición | Bolivia | — | 2024 |
| XXV Curso Internacional Alexander Hollaender – ALAG | Estefani Huanca | Exposición | Bolivia | — | 2024 |
| II Escuela de Verano TYAN-TWAS | Estefani Huanca | Exposición | Bolivia | — | 2024 |
| II Congreso Boliviano de Biología Molecular | Daniel Salas Veizaga | Exposición | Bolivia | — | 2024 |
| I Simposio de Resistencia Antimicrobiana | Daniel Salas Veizaga, Karin Hjort, Marcelo Gutiérrez, María Teresa Álvarez | Exposición | Bolivia | — | 2024 |
| Conferencia Universidad del Valle | Daniel Salas Veizaga | Exposición | Bolivia | — | 2024 |
| Conferencia Sociedad Científica de Estudiantes de Ingeniería Química, Alimentos y Ambiental | Daniel Salas Veizaga, Yuran Calancha | Exposición | Bolivia | — | 2024 |
Cursos organizados
Actividades académicas 2022–2024| Nombre del curso | Gestión |
|---|---|
| Introducción a la metagenómica | 2022 |
| Curso Intensivo – Bioinformática y Metagenómica en los Andes | 2023 |
| Escherichia coli como fábrica de proteínas recombinantes (Curso teórico-práctico en Ingeniería Genética) | 2023 |
| Biotecnología (curso anual) | 2024 |
| Conceptos básicos de R Studio para principiantes | 2024 |
| Llamado de bases a partir de datos de secuenciación de nueva generación (NGS) | 2024 |
| Introducción a la Ingeniería Genética | 2024 |
| Diseño de primers con fines ambientales (Primer design for environmental purposes) | 2024 |
| Diseño de primers con fines clínicos (Primer design for clinical purposes) | 2024 |
| Resistencia antimicrobiana en el contexto One Health: mecanismos de transmisión, diagnóstico y estrategias de mitigación (estudios IIFB–UMSA) | 2024 |
Premios y Distinciones
Reconocimientos obtenidos 2022–2025| Tipo | Representante(s) | Fecha | Evento / Convocatoria | Institución que otorga | Motivo del reconocimiento |
|---|---|---|---|---|---|
| Premio | Calancha Padron Yuran | 01/11/2025 | Premio Plurinacional de Ciencia y Tecnología | Ministerio de Desarrollo Productivo | 1er Lugar en el área Jóvenes Investigadores |
| Premio | Perez Condori Dayana | 01/11/2025 | Premio Plurinacional de Ciencia y Tecnología | Ministerio de Desarrollo Productivo | 2do Lugar en el área Jóvenes Investigadores |
| Premio | Huanca Guzmán Estefani | 01/01/2024 | Sociedad Científica de Estudiantes – Facultad de Ciencias Farmacéuticas y Bioquímicas | Sociedad Científica de Estudiantes FCFB – Filial La Paz | Reconocimiento al mérito académico por la investigación en endolisinas como potenciales enzibióticos |
| Premio | Huanca Guzmán Estefani | 01/01/2024 | XXVIII Congreso Boliviano Científico de Estudiantes de Ciencias Farmacéuticas y Bioquímicas (COBOLCEFYB) | Comité organizador del XXVIII COBOLCEFYB | Reconocimiento a la calidad de investigación y presentación de resultados en congreso científico estudiantil |
| Premio | Calancha Padron Yuran Elias | 01/07/2023 | Jornadas Científicas Julianas | Facultad de Ciencias Farmacéuticas y Bioquímicas – UMSA | Reconocimiento al mejor trabajo presentado – Primer lugar |
| Premio | Perez Condori Dayana | 02/07/2023 | Jornadas Científicas Julianas | Facultad de Ciencias Farmacéuticas y Bioquímicas – UMSA | Reconocimiento al segundo mejor trabajo presentado – Segundo lugar |
| Premio | Chuilla Condori Abigail | 03/07/2023 | Jornadas Científicas Julianas | Facultad de Ciencias Farmacéuticas y Bioquímicas – UMSA | Reconocimiento al tercer mejor trabajo presentado – Tercer lugar |
| Premio | Rocabado Villegas Leonardo Roberto | 04/07/2023 | Jornadas Científicas Julianas | Facultad de Ciencias Farmacéuticas y Bioquímicas – UMSA | Invitación especial por trayectoria y aporte académico |